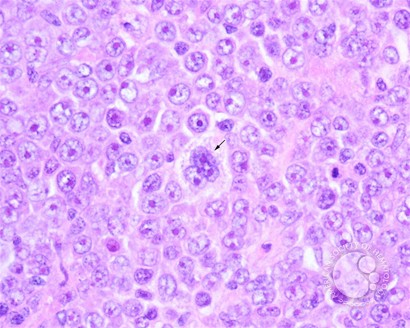
sanamloghavi's tweet image. Diffuse Large B-cell Lymphoma, Anaplastic Variant submitted by John Lazarchick. IHC shows diffuse strong CD20 expression.  #MedEd #Hematology #ASHImageBank #hemepath 🔬🧬 @artsinyc @KMirza @ASH_hematology  imagebank.hematology.org/image/1992
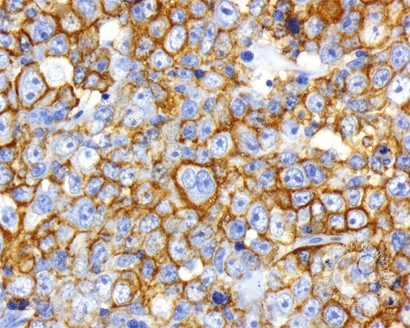
sanamloghavi's tweet image. Diffuse Large B-cell Lymphoma, Anaplastic Variant submitted by John Lazarchick. IHC shows diffuse strong CD20 expression.  #MedEd #Hematology #ASHImageBank #hemepath 🔬🧬 @artsinyc @KMirza @ASH_hematology  imagebank.hematology.org/image/1992

#meded search results
🧠 Rheumatology MCQ Recurrent miscarriages + stroke Plt 85k, aPTT prolonged Long-term Rx? A Aspirin B Warfarin C DOAC D Steroids ⚠️ Common mistake here #Rheumatology #APS #MedEd @docakx @DocPriyamMD @DrNikhilMD @IhabFathiSulima @APSFA

🧴 From acne to scabies — here’s what every doctor (and patient) should recognize early. #SkinConditions #DermatologyNotes #MedEd #Healthcare #ClinicalMedicine #DoctorTips

Not every tremor needs treatment. Not every tremor is Essential Tremor. And not every failure is drug-resistant. Here’s a clean, practical OPD roadmap you should use to approach essential tremor 👇 #EssentialTremor #Neurology #MedEd #ClinicalPearls #BrainHealth #Neurotwitter

A 50yr♂️ presented with chronic cough X 2 months,bloody sputum,chest pain and SOB.CXR done👇He was previously treated for TB,but symptoms have not improved.He reports eating undercooked fresh water crabs #MedTwitter #MedX #MedEd #FOAMed #GITwitter #IDTwitter #CardioTwitter

New England Journal of Medicine (NEJM) 2026: Esófago de Barret DOI:10.1056/NEJMcp2506887 #MedEd #MedTwitter #MedX medicina-interna.org




🩸 Hematology Pearl Pancytopenia? Don’t jump to leukemia. 🔍 Consider: • Aplastic anemia • B12 deficiency • Hypersplenism 💡 Bone marrow exam often needed. #Hematology #MedEd #Pancytopenia #medtwitter
🧠 Rheumatology MCQ Hematuria + hemoptysis + rapid AKI RBC casts CXR infiltrates Anti-GBM + Next step? A Steroids B Steroids + CYC C PLEX + steroids + CYC D Anticoagulation #Rheumatology #AntiGBM #MedEd @docakx @IhabFathiSulima @DocPriyamMD @DrNikhilMD

Case courtesy of Alexander Enabnit, OMS II; Kyran Hines, OMS-I; James Adams, DO | ATSU-KCOM View more👉aocr.org/page/caseofthe… #radiology #AOCR #MedEd #RadRes #RadFellow #radiologist #radiologylearning #radiologylife #caseoftheweek
HIV patient with CD4 cell counts <100/μL what is the diagnosis ? Treatment? #MedX #MedTwitter #MedEd #CardioTwitter #GITwitter #DermTwitter #IDTwitter @albertoortegana @Ausbones @ChefKarim02 @daoo100 @Doctors__squad @DrMedica_13 @doctors_squad @MEmwanta @mendietaalex1

🧠 Rheumatology MCQ SLE + acute abdomen Amylase/lipase ↑ (mild) D-dimer ↑ CT: target sign Next step? A Anticoagulation B Steroids C Surgery D Antibiotics #Rheumatology #SLE #MedEd @docakx @DrOribaDan @IhabFathiSulima @drkeithsiau @DrNikhilMD

🧠 Rheumatology MCQ Confusion + fever + petechiae Hb 8.5 | Plt 18k | LDH↑ Smear: schistocytes Next best step? A Anticoagulation B Steroids C Plasma exchange D IVIG #Rheumatology #TTP #MedEd @docakx @IhabFathiSulima

Visit Bestusmletutor.com today and Schedule your Free USMLE Tutoring consultation. #USMLE #MedEd #MedX #BestUSMLETutor
11 años♀️, dermatitis atópica, tras picaduras de mosquitos, durante un viaje a Bosnia: lesiones eritematosas pruriginosas, que se han extendido, con aparición de costras y placas con vesículas. 1/2 🖋️ López E, Barchino LM. continuum.aeped.es #pediatria #MedEd


🧠 Rheumatology MCQ SLE + fever + hypotension + AMS Plt 55k, Cr 2.2 Procalcitonin ↑ Next step? A Steroids B Broad-spectrum antibiotics C Cyclophosphamide D Anticoagulation #Rheumatology #ICU #MedEd @docakx @IhabFathiSulima

62-year-old woman with a 2-month history of a nonproductive cough receives this chest radiograph. - What’s the diagnosis ? #medtwitter #foamed #meded #foamrad

JAMA 2026: Consejería preconcepcional doi:10.1001/jama.2026.2888 #MedEd #MedTwitter #MedX medicina-interna.org



🧠 Rheumatology MCQ — Clinical Trap Fever + arthralgia + salmon rash Ferritin 12,000 ANA/RF negative Best initial treatment? A MTX B NSAIDs ± steroids C Rituximab D Cyclophosphamide #Rheumatology #AOSD #MedEd @docakx @IhabFathiSulima

An unusual cause of chest pain 🩺 Do you agree with the working diagnosis for this patient with chest pain and orthopnoea? Share your thoughts on MedShr: medshr.it/rZbQ8yUClBb #FOAMed #CPD #MedEd #PatientCare
HOCM murmur maneuvers and clinical presentation USMLE #USMLEStep1 #MedEd #Cardiology #HOCM #HeartMurmur #PhysicalExam #MedicalStudent #Step1Prep #HighYield #MedSchool #InternalMedicine #Cardiovascular #FutureDoctor #StudyGram #MedTwitter #Anki #BoardExam mymedschool.org/portfolio/u01-…
Pathophysiology and murmur maneuvers of HOCM USMLE Step 1 #USMLEStep1 #MedEd #Cardiology #Pathology #HOCM #SuddenCardiacDeath #Cardiovascular #Step1Prep #HighYield #MedSchool #InternalMedicine #Genetics #Sarcomere #FutureDoctor #StudyGram #MedTwitter #An mymedschool.org/portfolio/u01-…
EKG findings and pathophysiology of Wolff-Parkinson-White syndrome USMLE #USMLEStep1 #MedEd #Cardiology #WPW #Arrhythmia #EKG #Electrocardiogram #Step1Prep #HighYield #MedSchool #InternalMedicine #PreExcitation #BundleOfKent #FutureDoctor #StudyGram #Med mymedschool.org/portfolio/u01-…
Struggling to decode ventilator alarms? This quick guide breaks down exactly what high-pitched vs. low-pitched alarms mean for airway safety. Essential viewing for healthcare pros! #MedEd #RespiratoryTherapy #VentilatorAlarms #NursingEducation
Pathophysiology of myocardial rupture 3 to 14 days post MI USMLE #USMLEStep1 #MedEd #Cardiology #Pathology #MyocardialInfarction #CardiacRupture #HeartAttackComplications #Step1Prep #HighYield #MedSchool #InternalMedicine #CardiologyFellow #FutureDoctor mymedschool.org/portfolio/u01-…
Grand Rounds by Dr. Briana Castillo, Director of Microbiology Processing on the 5-day blood culture incubation standard—showing most clinically significant isolates are detected within 3 days,with implications for optimizing lab workflows and patient care #ID #MedEd #Microbiology




So proud of our fellows and faculty for their outstanding participation at DDW 2026! 👏🔬 🌟 Come connect with our team at DDW and celebrate the incredible work shaping the future of GI! @DDWMeeting #DDW2026 #GITwitter #MedEd

📊 Are your EPSDT practices optimized? Strengthen screening, documentation, and care coordination for better outcomes. 👉 cmeo.me/SNE-292 #Medicaid #HealthcareQuality #MedEd
🌸Open Access in @AcadMedJournal 🌸 Belonging isn’t a “nice to have”—it shapes who stays, leads, and thrives in medicine. This piece highlights how student-led disability orgs are building community, mentorship, and change. Read: bit.ly/AcadMed_Critic… #MedEd #Belonging

Top “don’t-miss” publications highlighted at the ABE course ahead of @DDWMeeting 👉🏼 Innovative endoscopic therapies showing real metabolic impact 📉 Definitely shaping future GI practice! #ddw2026 #GiTwitter #MedEd @ASGEendoscopy

Stay up on the role of blood-based biomarkers in Alzheimer’s disease and earn CME credits! Explore PeerView’s AD Biomarkers Learning Center for activities, videos, and downloadable resources: bit.ly/APOE #AlzheimersDisease #MedEd #APOE

📋 IDSA 2023: This updated guideline provides recommendations for the diagnosis and treatment of blastomycosis, a systemic fungal infection endemic to certain regions. 📚 pccmfellows.com/?utm_source=tw… #PCCM #MedEd #CriticalCare
📋 GINA 2023: This report details the latest evidence and recommendations for asthma management, including diagnostic criteria, treatment algorithms, and strategies for managing severe asthma and exacerbations. 📚 pccmfellows.com/?utm_source=tw… #PCCM #MedEd #CriticalCare
📋 IDSA 2016: Use evidence-based strategies for diagnosing, treating, and preventing hospital-acquired and ventilator-associated pneumonia in adults. 📚 pccmfellows.com/?utm_source=tw… #PCCM #MedEd #CriticalCare
NK Video Podcast #1 of 2 | Senseless Progression: Cracking the Code of Neurotrophic Keratitis | 0.75-hour CME/CE | Recorded at AAO 2025 | Watch it Now! | #MedEd #cme #NeurotrophicKeratitis | bit.ly/474zTAn

Case courtesy of Alexander Enabnit, OMS II; Kyran Hines, OMS-I; James Adams, DO | ATSU-KCOM View more👉aocr.org/page/caseofthe… #radiology #AOCR #MedEd #RadRes #RadFellow #radiologist #radiologylearning #radiologylife #caseoftheweek
🚨 Clinical Update: As we head into the second half of 2026, the rise of GLP-1s for expanded indications (cardiovascular/kidney) is reshaping our counseling sessions. Is your pharmacy seeing a shift in patient demographics for these scripts? #PharmacyUpdates #PharmaNews #MedEd
Textbook mature AV fistula with aneurysmal dilatation. High-flow access is essential for dialysis, but the thinned overlying skin raises concern for rupture. 🏥 #Nephrology #MedEd
Rethinking ultra-processed foods: Controversies, health evidence, and policy directions Open Access doi.org/10.59717/j.xin… #UPF #food #meded #medx

Did you know? 👇 Hypoglycaemia isn’t just “low sugar” — it’s a medical emergency ⚠️ Missed meals + insulin = danger ⚠️ Delayed recognition = brain injury Recognize early. Treat immediately. #DiabetesEducation #InsulinTherapy #MedEd #Healthcare

Controlling confounding in nutrition research: Methodological strategies, software implementation, and reporting guidelines Open Access doi.org/10.59717/j.xin… #nutrition #meded #medx #statistics

A 50yr♂️ presented with chronic cough X 2 months,bloody sputum,chest pain and SOB.CXR done👇He was previously treated for TB,but symptoms have not improved.He reports eating undercooked fresh water crabs #MedTwitter #MedX #MedEd #FOAMed #GITwitter #IDTwitter #CardioTwitter

🧴 From acne to scabies — here’s what every doctor (and patient) should recognize early. #SkinConditions #DermatologyNotes #MedEd #Healthcare #ClinicalMedicine #DoctorTips

🧠 Rheumatology MCQ Recurrent miscarriages + stroke Plt 85k, aPTT prolonged Long-term Rx? A Aspirin B Warfarin C DOAC D Steroids ⚠️ Common mistake here #Rheumatology #APS #MedEd @docakx @DocPriyamMD @DrNikhilMD @IhabFathiSulima @APSFA

Perspective by J.A. Greene et al.: A Eulogy for Structural Competence? nej.md/4tCoMrC #HealthPolicy #MedEd

Not every tremor needs treatment. Not every tremor is Essential Tremor. And not every failure is drug-resistant. Here’s a clean, practical OPD roadmap you should use to approach essential tremor 👇 #EssentialTremor #Neurology #MedEd #ClinicalPearls #BrainHealth #Neurotwitter

Fasting-mimicking diet offers new ways for crohn’s diseases management Open access science.org/doi/10.1126/sc… #meded #medx #diet

🩸 Anemia — don’t ignore the silent fatigue. 📉 Low Hb = low oxygen delivery ⚠️ Look beyond numbers → find the cause 🔍 MCV guides diagnosis (micro / normo / macro) 💊 Treat deficiency, not just symptoms 👉 Early detection = better outcomes #Anemia #MedEd #Pathology

New England Journal of Medicine (NEJM) 2026: Esófago de Barret DOI:10.1056/NEJMcp2506887 #MedEd #MedTwitter #MedX medicina-interna.org




🧠 Rheumatology MCQ SLE + acute abdomen Amylase/lipase ↑ (mild) D-dimer ↑ CT: target sign Next step? A Anticoagulation B Steroids C Surgery D Antibiotics #Rheumatology #SLE #MedEd @docakx @DrOribaDan @IhabFathiSulima @drkeithsiau @DrNikhilMD

Superimposed Pressure for Predicting Mortality in Acute Respiratory Failure During Spontaneous Breathing: Insights From the CT-COVID19 Multicenter Study Group Read the research in the recent issue of #journal_CHESTCritCare: hubs.la/Q04dWQ9Z0 #MedEd #JournalCHEST

🧠 Rheumatology MCQ Hematuria + hemoptysis + rapid AKI RBC casts CXR infiltrates Anti-GBM + Next step? A Steroids B Steroids + CYC C PLEX + steroids + CYC D Anticoagulation #Rheumatology #AntiGBM #MedEd @docakx @IhabFathiSulima @DocPriyamMD @DrNikhilMD

Diffuse Large B-cell Lymphoma, Anaplastic Variant submitted by John Lazarchick. IHC shows diffuse strong CD20 expression. #MedEd #Hematology #ASHImageBank #hemepath 🔬🧬 @artsinyc @KMirza @ASH_hematology imagebank.hematology.org/image/1992

Revisiting computational immunogenicity prediction for novel food ingredients Open Access doi.org/10.59717/j.xin… #Meded #medx #Food #Science #NEWS #Health #AI #artificialintelligence #Immunity #immunogenicity #biology

Something went wrong.
Something went wrong.
United States Trends
- 1. #LakeShow N/A
- 2. #SmackDown N/A
- 3. RJ Barrett N/A
- 4. Toronto N/A
- 5. Magic N/A
- 6. McAvoy N/A
- 7. Sengun N/A
- 8. Cavs N/A
- 9. Amen Thompson N/A
- 10. Game 7 N/A
- 11. #ForgedInGold N/A
- 12. #OPLive N/A
- 13. Mobley N/A
- 14. Raptors N/A
- 15. #Lakers N/A
- 16. Benson N/A
- 17. Pistons N/A
- 18. Bruins N/A
- 19. Reed Sheppard N/A
- 20. Thunder in 4 N/A


















































































